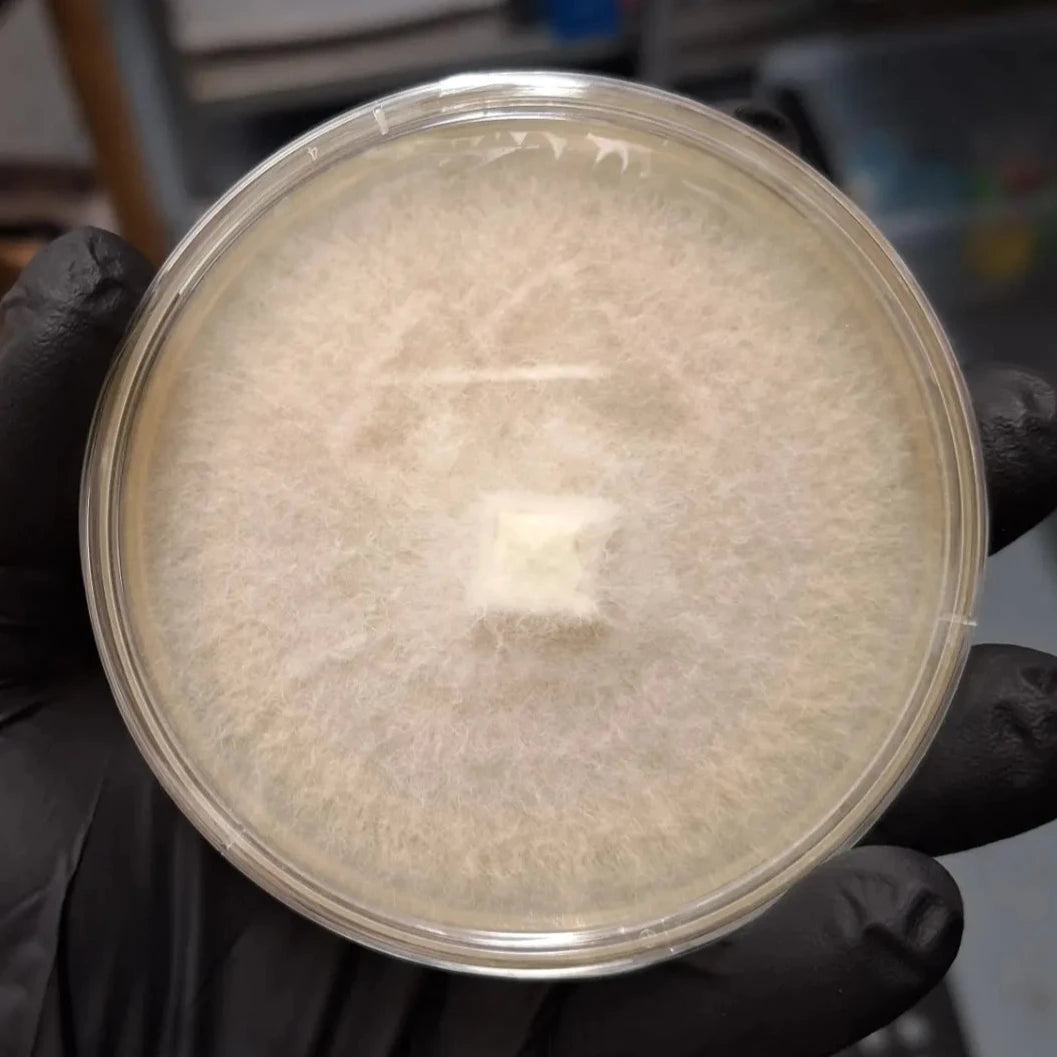
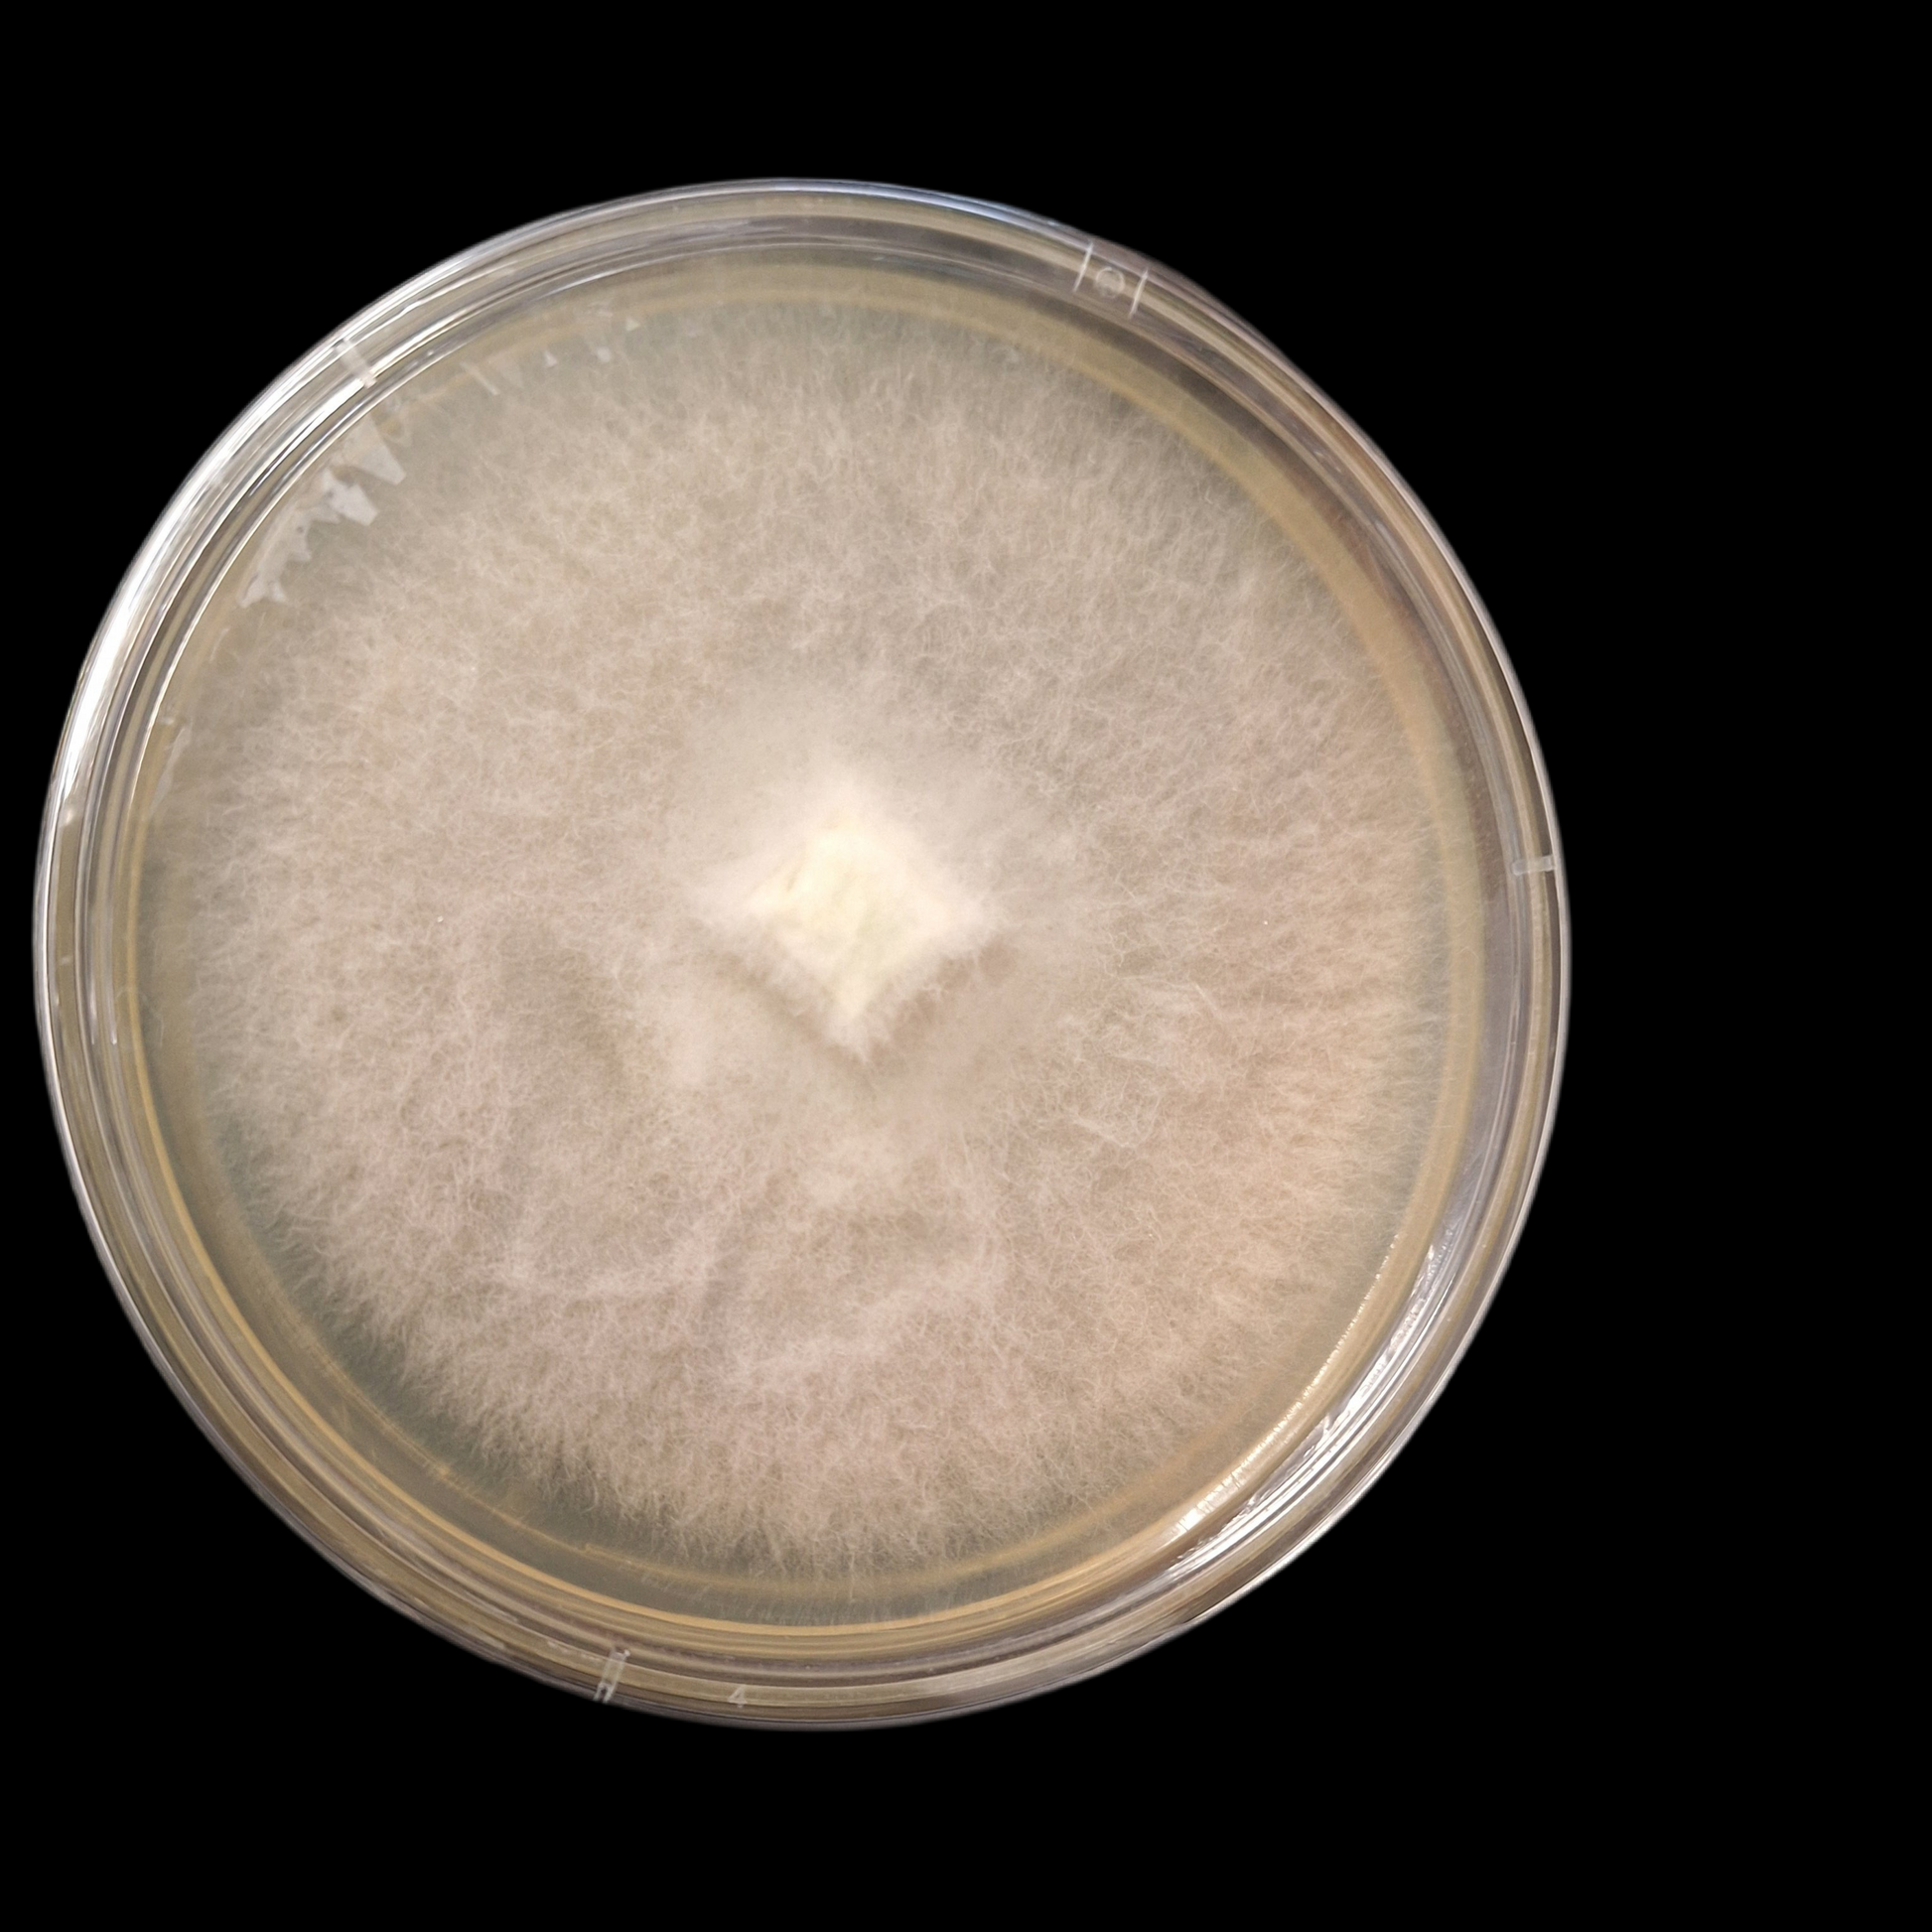
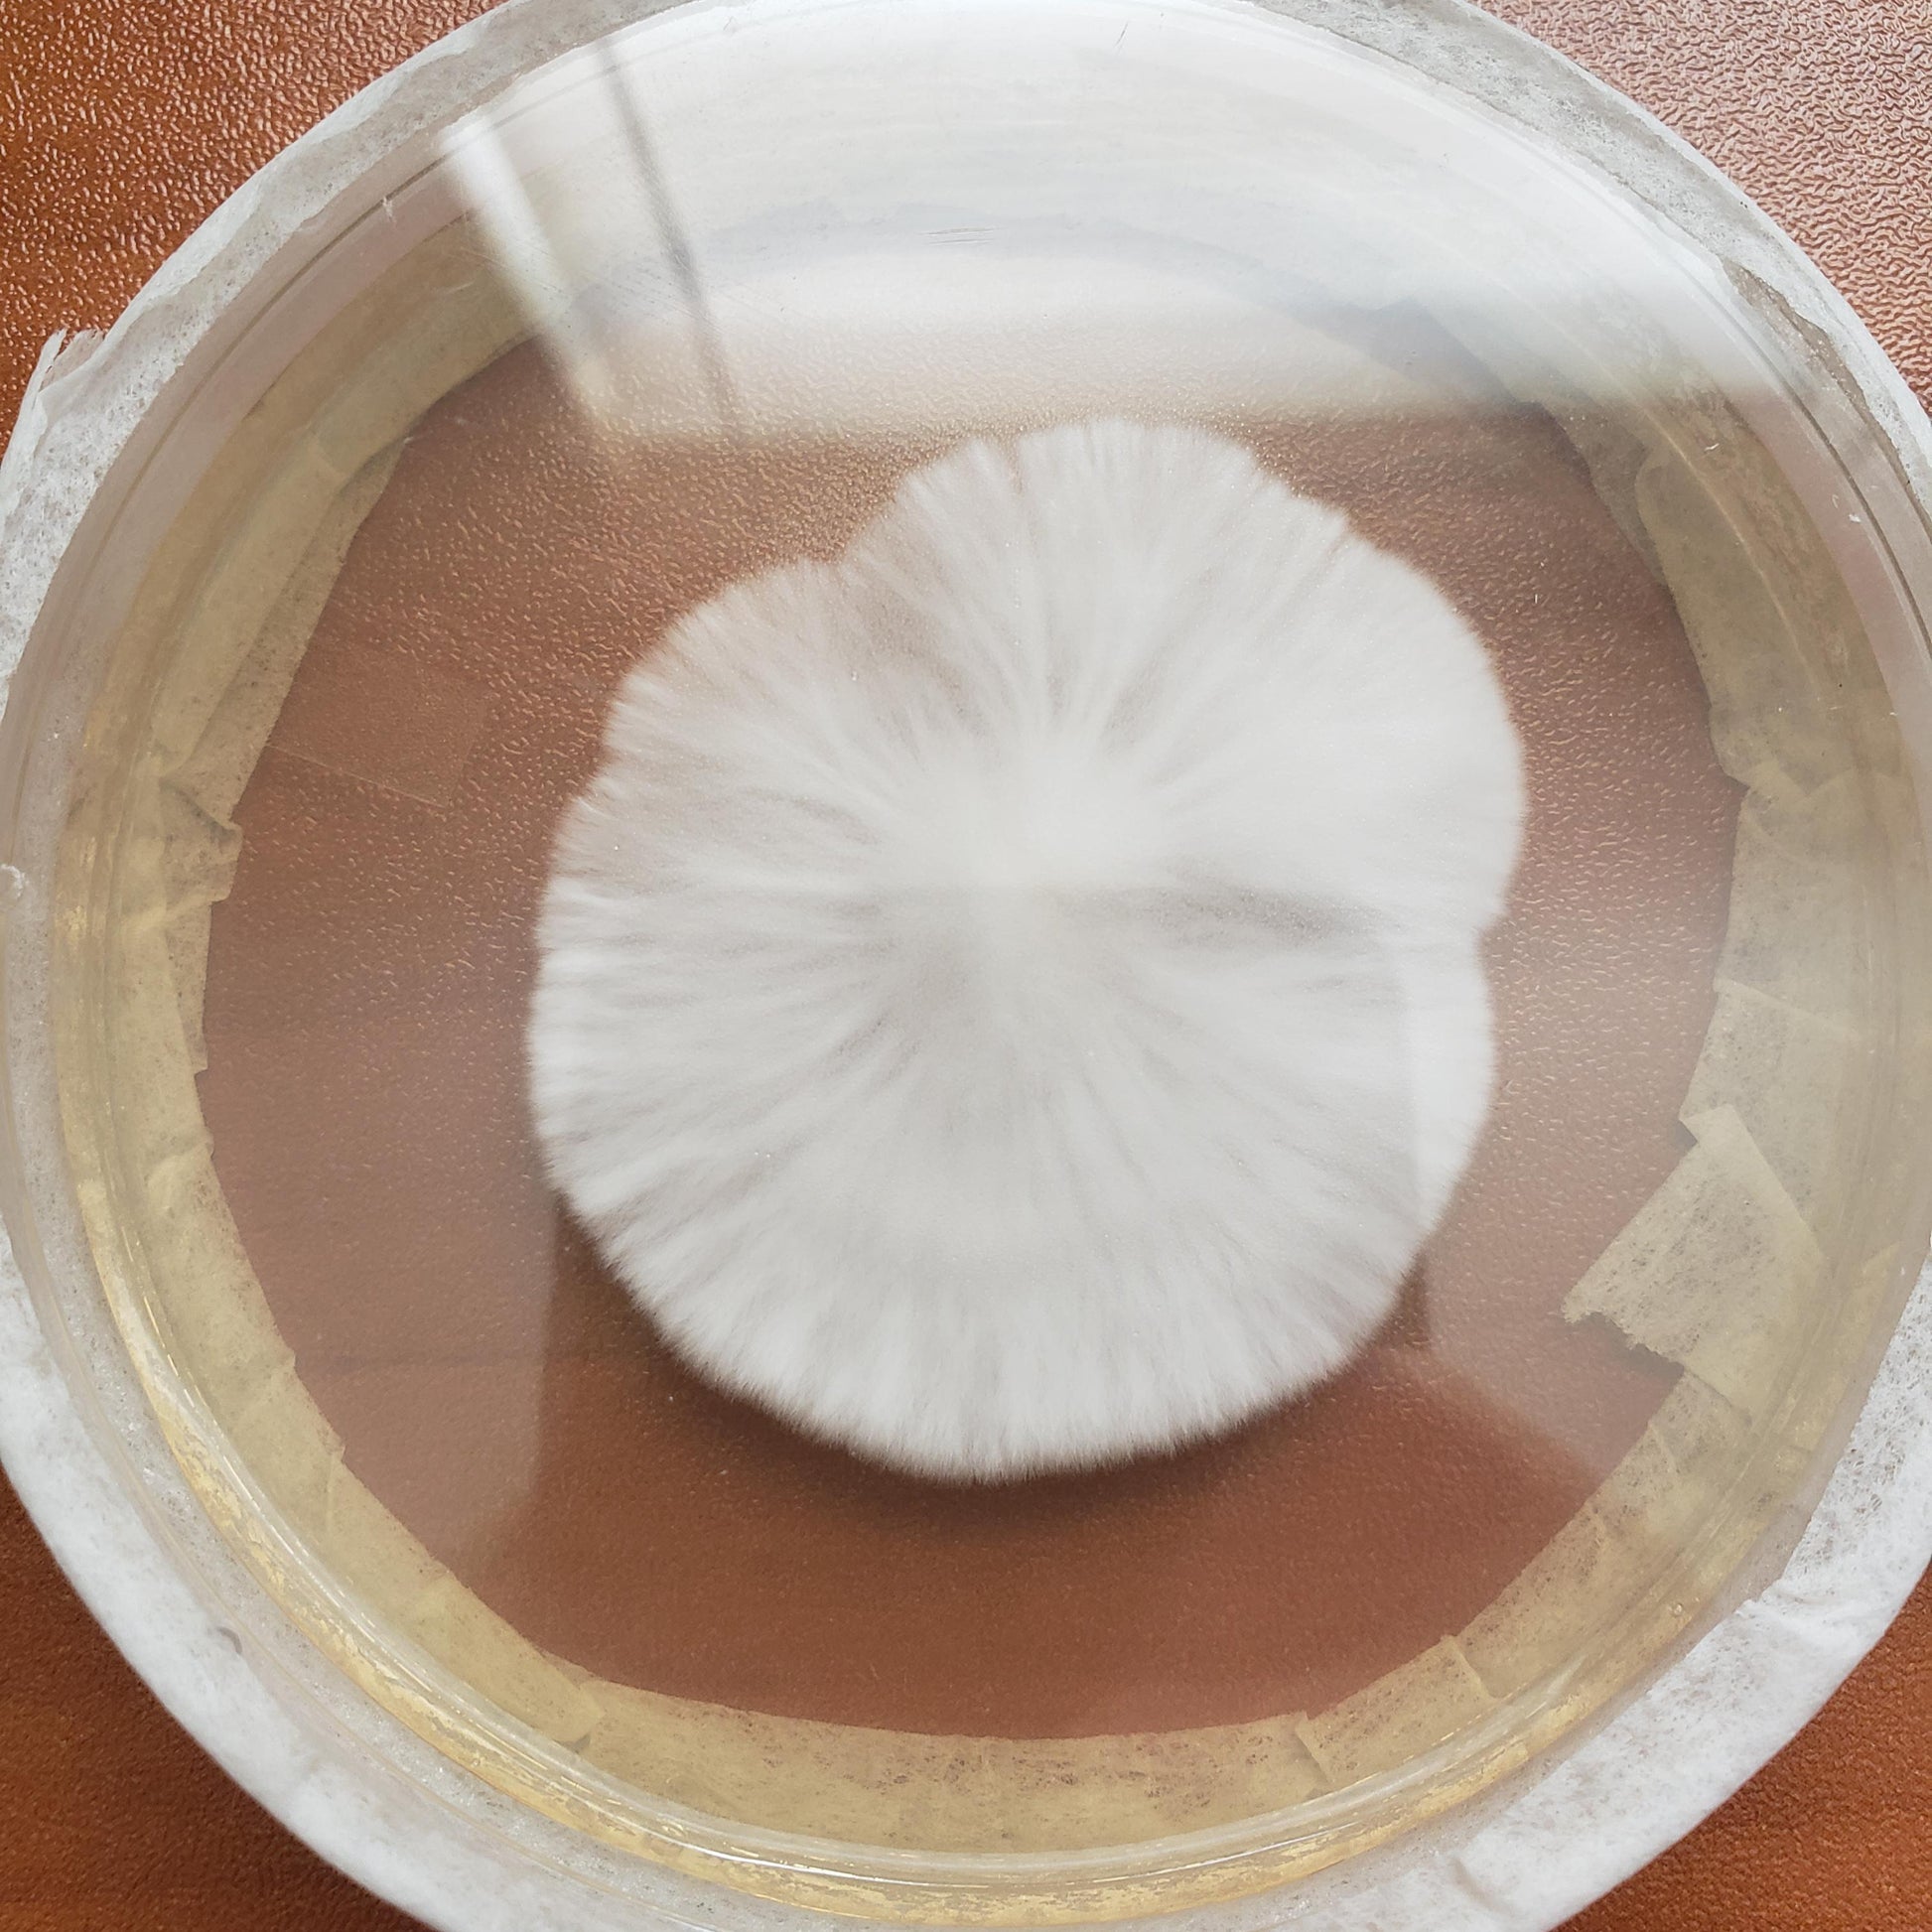

Jurassic Coast Mushrooms
Colonised Agar Plates
Colonised Agar Plates
Couldn't load pickup availability
Fully Colonised Agar Plate Culture.
Agar plate cultures are the perfect choice to further expand to liquid culture or to fresh Agar plates, in order to produce your own grain spawn, fruiting blocks and to ultimately grow your own gourmet mushrooms!
All plates are freshly made and contain vigorous growing mycelium, these have not been sat dormant in the fridge, they’ll be ready to use upon arrival.
Petri dishes are prepared in front of a Laminar flow hood, within our spawn lab to ensure aseptic conditions, perfect for inoculating grain, expanding to liquid culture or transferring to new plates to expand the culture further.
What you'll receive -
- 1 x Fully Colonised Agar Plate
- 1 x IPA wipe
By choosing a native culture, you're not only going to be rewarded with yummy mushrooms but you will also be playing your role in preserving native mushrooms.